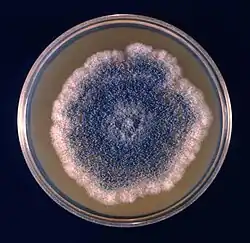

Aspergillus clavatus
![]() Główki konidialne A. clavatus | |
| Systematyka | |
| Domena | |
|---|---|
| Królestwo | |
| Typ | |
| Klasa | |
| Rząd | |
| Rodzina | |
| Rodzaj | |
| Gatunek |
Aspergillus clavatus |
| Nazwa systematyczna | |
| Aspergillus clavatus Desm. Annls Sci. Nat., Bot. sér. 2 2: 71 (1834) | |
Aspergillus clavatus Desm. – gatunek grzybów z rodziny kropidlakowatych (Aspergillaceae)[1]. Mikroskopijny grzyb chorobotwórczy[2].
Systematyka i nazewnictwo
Pozycja w klasyfikacji według Index Fungorum: Aspergillus, Aspergillaceae, Eurotiales, Eurotiomycetidae, Eurotiomycetes, Pezizomycotina, Ascomycota, Fungi[1].
Takson ten opisał Jean Baptiste Henri Joseph Desmazières w 1834 r.[1] Synonim: Aspergillus clavatus var. major Torrend 1914[3]:
Charakterystyka
A. clavatus jest prawdopodobnie gatunkiem kosmopolitycznym. Występuje głównie w glebie i odchodach, ale również na produktach magazynowanych (głównie zbożach) w dużej wilgotności, np. na nieodpowiednio przechowywanym ryżu, kukurydzy i prosie. Izolaty A. clavatus wydają się być szczególnie dobrze przystosowane do wzrostu podczas słodowania[2].
Po siedmiu dniach kolonia hodowana na podłożu CYA25 osiąga średnicę 28–45 mm, na MEA 25: 25–44 mm, YES25: 29–45 mm, OA25: 31–47 mm, CYA37: 9–26 mm, CREA25: bardzo dobry wzrost, produkcja kwasu od umiarkowanej do bardzo silnej. Kolor kolonii: niebiesko-zielony. Rewers na podłożu (CZA) u niektórych izolatów z wiekiem bezbarwny do nieco brązowawego. Zarodnikowanie obfite. Konsystencja kolonii: aksamitna. Główka konidialna maczugowata, zwykle o wymiarach od 300–400 × 150–200 μm w młodym wieku, z wiekiem zwykle dzieli się na dwie, trzy lub więcej rozbieżnych kolumn. Konidiofor o długości 1500–3000 μm i średnicy 20–30 μm. Jego pęcherzyk jest maczugowaty o wymiarach 200–250 × 40–60 μm. Konidia gładkie, eliptyczne 3–4,5 × 2,5–3 μm[2].
Cecha diagnostyczna A. clavatus: główki konidialne o wielkości do 4 mm. Podobny jest Aspergillus clavatonanicus[2].
Własności chorobotwórcze
A. clavatus jest jednym z gatunków rodzaju Aspergillus wywołującym aspergilozę. Jest odpowiedzialny za zewnętrzne alergiczne zapalenie pęcherzyków płucnych znane jako płuca robotnika słodowego. Opisuje się je jako prawdziwe zapalenie płuc z nadwrażliwości, które zwykle występuje u pracowników słodu. Powoduje gorączkę, dreszcze, kaszel i duszność[4]. Wytwarzane przez A. clavatus mykotoksyny powodują zatrucie zwierząt karmionych produktami ubocznymi słodowania. Sugerowano, że toksyczne zespoły obserwowane u zwierząt wynikają z synergistycznego działania różnych mykotoksyn wytwarzanych przez ten gatunek[2]. Szczep A clavatus spowodował również nadmierne rogowacenie u cieląt[5].
Zastosowanie
- W marcu 1942 roku Weisner po raz pierwszy odnotował wytwarzanie przez szczepy A. clavatus antybiotyku, któremu nadano nazwę clavatin. Później antybiotyk ten został nazwany clavacinem. Znany jest również pod nazwą patulina. Jest cennym lekiem w leczeniu przeziębienia i wywiera działanie grzybostatyczne lub grzybobójcze na niektóre dermatofity[5].
- A. clavatus wytwarza cytochalazynę E, cytochalazynę K, tryptokwiwalinę, nortryptokwiwalon, nortryptokwiwalinę, deoksytryptokwiwalinę, deoksynortryptokwiwalinę, tryptokwiwalinę E i tryptokwiwalinę N[6].
- Izolaty A. clavatus wytwarzają rybotoksyny, które mogą pomóc w opracowaniu procesów immunoterapii raka[7].
- A. clavatus wykorzystywany jest także do tworzenia pozakomórkowych bionanocząstek z roztworów azotanu srebra. Wykazują one właściwości przeciwdrobnoustrojowe, które działają przeciwko MRSA i MRSE[8].
Przypisy
- 1 2 3 Index Fungorum [online] [dostęp 2021-07-05] (ang.).
- 1 2 3 4 5 J. Varga i inni, Taxonomic revision of Aspergillus section Clavati based on molecular, morphological and physiological data, „Studies in Mycology, nr 59”, 2007, s. 89–106, DOI: 10.3114/sim.2007.59.11, PMID: 18490946, PMCID: PMC2275193 [dostęp 2021-06-22].
- ↑ Species Fungorum [online] [dostęp 2021-07-05] (ang.).
- ↑ Al-Doory. Laboratory Medical Mycology. Philadelphia: Lea and Febiger, Yousef, 1980.
- 1 2 Kenneth B. Raper, I. Dorothy, The Genus Aspergillus, Baltimore: The Williams and Wilkins Company, 1965, s. 137–146.
- ↑ R. Jarvis i inni, Handbook of secondary fungal metabolites, Amsterdam: Academic press, 2003, ISBN 978-0-12-179461-3.
- ↑ Katsuya Gomi, Aspergillus. Molecular biology and genomics, Wymondham, Norfolk: UK: Caister Academic, 2003, ISBN 978-1-904455-53-0.
- ↑ M. Saravanan, A. Nanda, Extracellular synthesis of silver bionanoparticles from Aspergillus clavatus and its antimicrobial activity against MRSA and MRSE, „Colloids and Surfaces B: Biointerfaces”, 77 (2), 2010, s. 214–218, DOI: 10.1016/j.colsurfb.2010.01.026.
